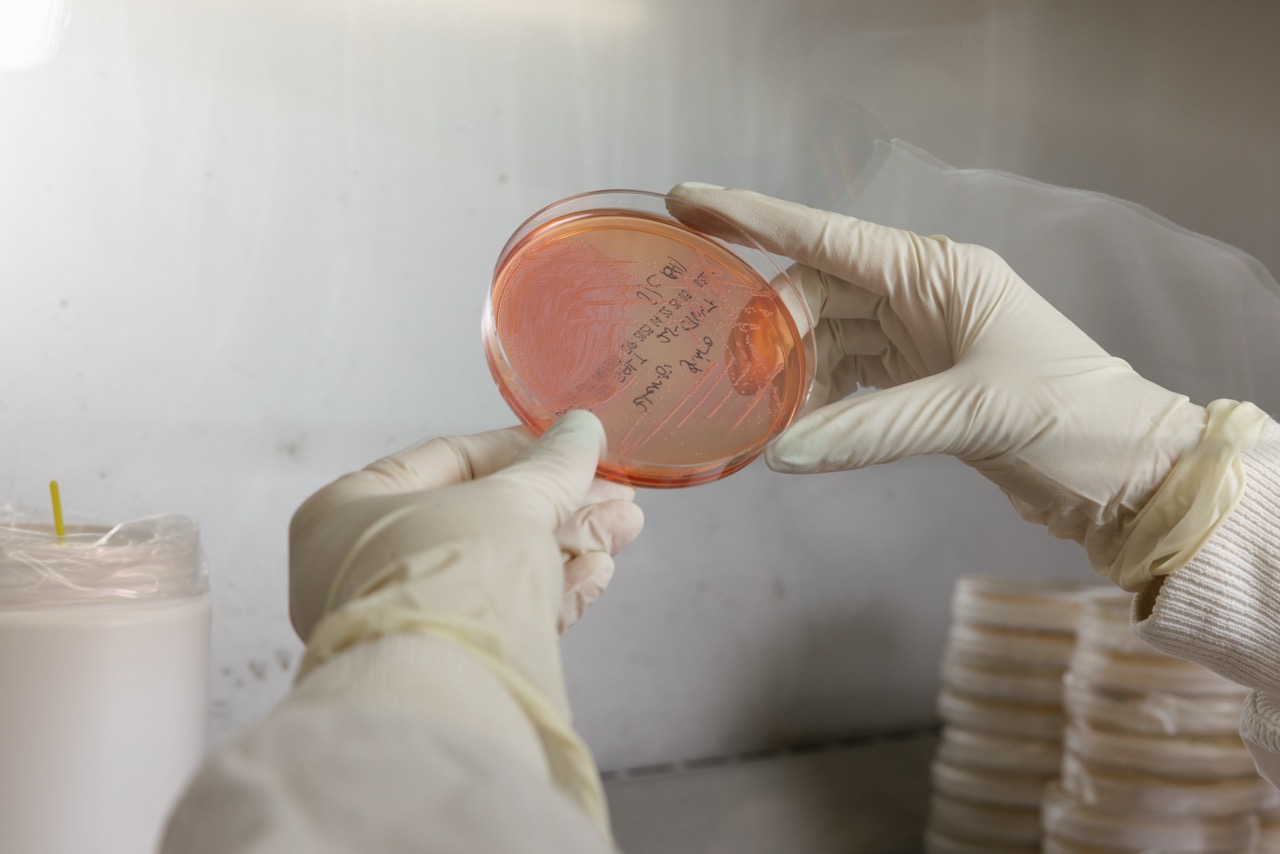

Latest News
-

Canine blood bank
Give the gift of life Dogs and their owners can give the gift of life to other dogs thanks to our blood bank at the University Veterinary Teaching Hospital Sydney.
-

Ancient spaghetti in dog hearts reveals origins of heartworm
Global DNA study rewrites the evolutionary history of canine disease.